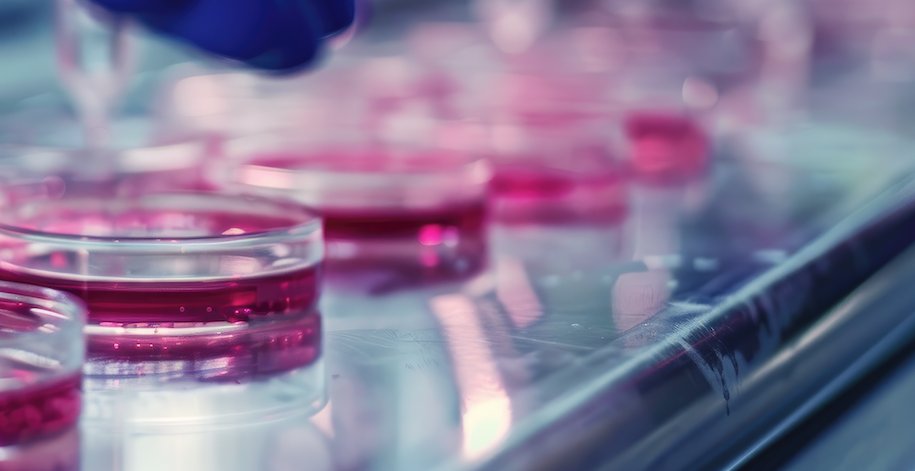
Transnetyx tweet media

Don’t miss our experts taking the stage at #AALAS2025!
Catch one (or all) of these info-packed sessions, then stop by booth #828 for more information on how our suite of services supports researchers in streamlining workflows, saving time, and advancing discoveries.
#Transnetyx

English